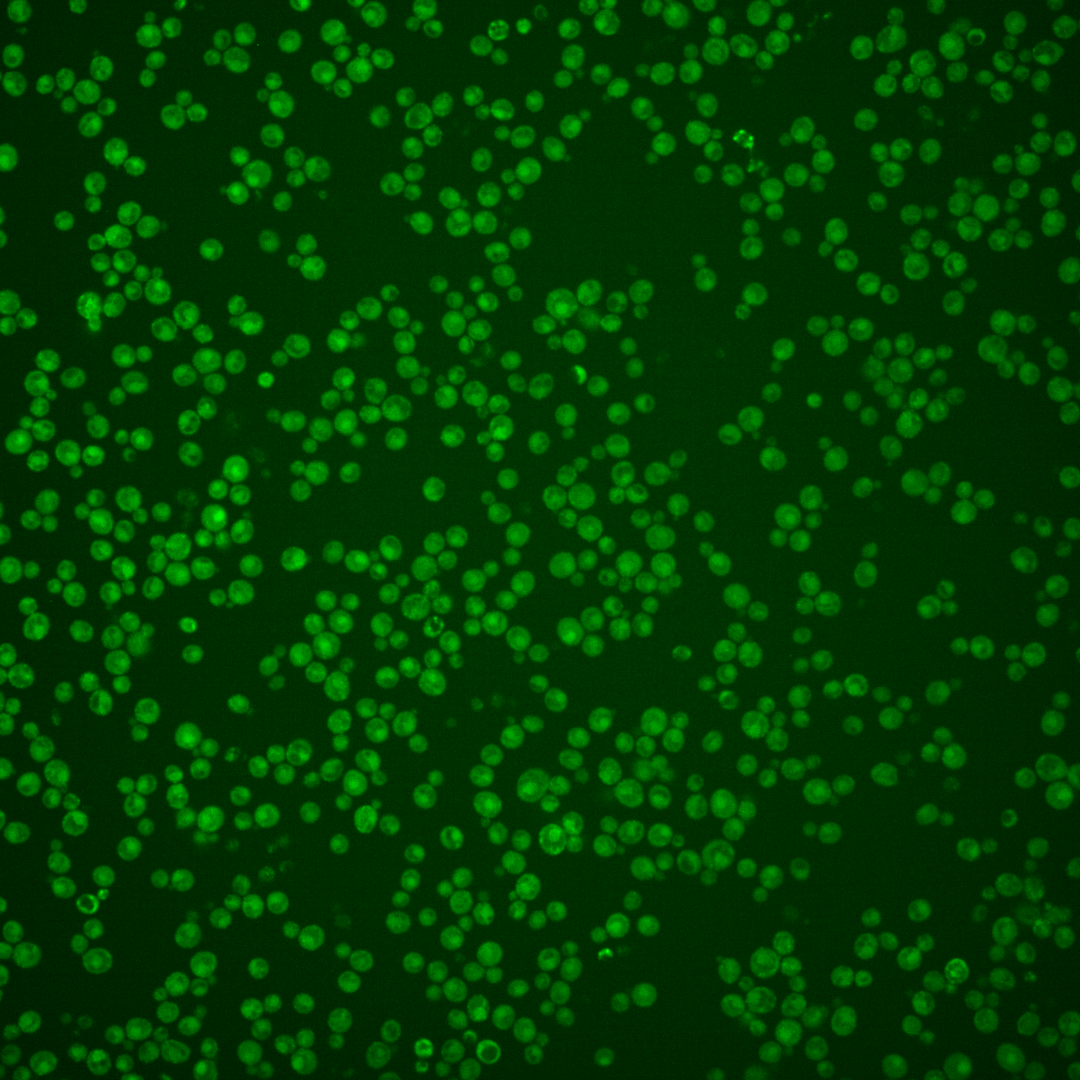
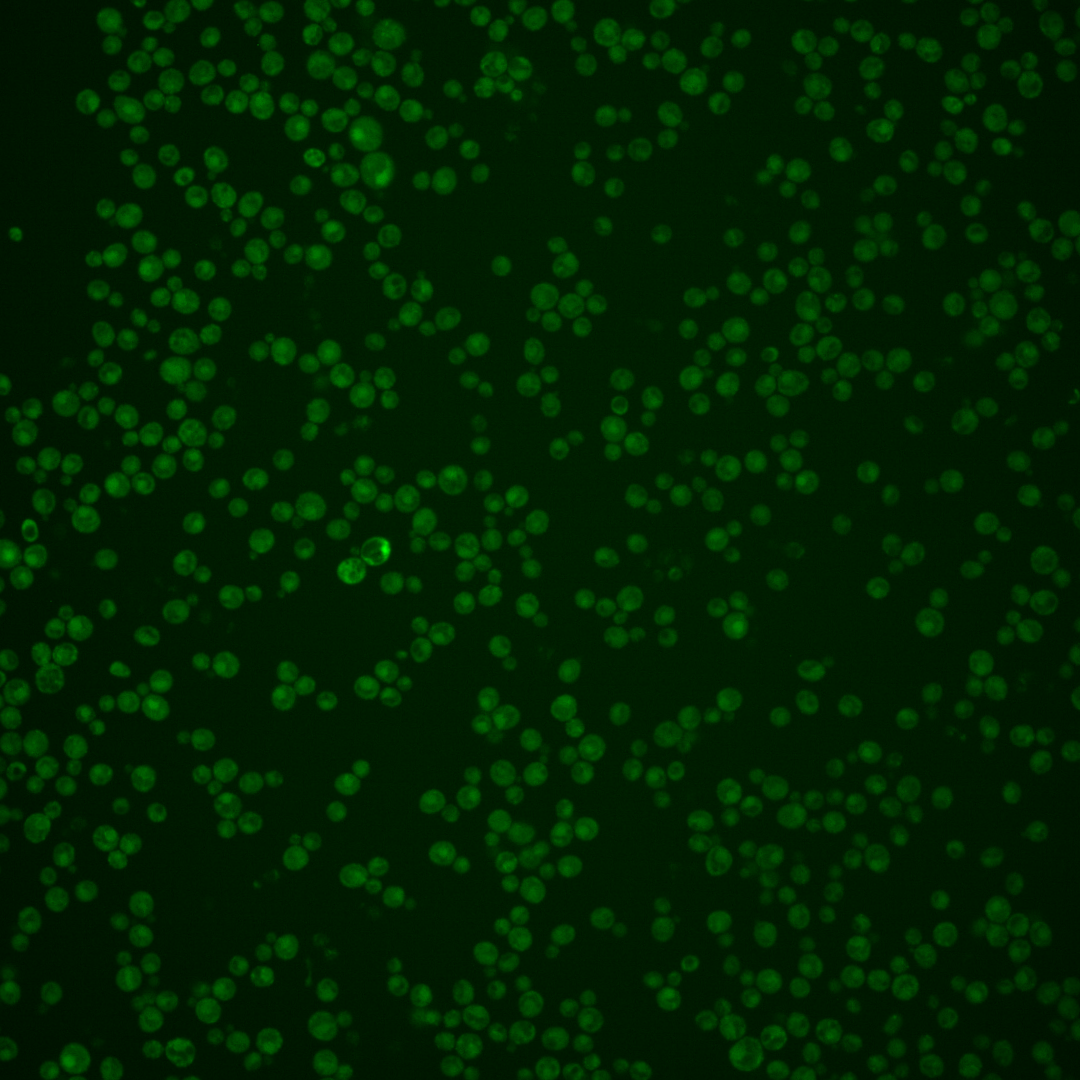

| Standard name | |
|---|---|
| Human Ortholog | |
| Description | Protein of unknown function; may be involved in mitochondrial DNA maintenance; required for slowed DNA synthesis-induced filamentous growth |
Micrographs




















































































Sub-cellular Localization
Yeast GFP Assignment
Protein Abundance
Localization Change
External localization resources
| ensLOC | DeepLoc | |||||||||||||||||||||||
|---|---|---|---|---|---|---|---|---|---|---|---|---|---|---|---|---|---|---|---|---|---|---|---|---|
| Localization | WT1 | WT2 | WT3 | RAP60 | RAP140 | RAP220 | RAP300 | RAP380 | RAP460 | RAP540 | RAP620 | RAP700 | HU80 | HU120 | HU160 | rpd3Δ_1 | rpd3Δ_2 | rpd3Δ_3 | WT1 | WT2 | WT3 | AF100 | AF140 | AF180 |
| Cortical Patches | 0 | 0 | 3 | 2 | 0 | 3 | 0 | 3 | 4 | 2 | 1 | 0 | 2 | 7 | 1 | 31 | 49 | 35 | 1 | 4 | 27 | 7 | 14 | 23 |
| Bud | 1 | 0 | 3 | 2 | 4 | 9 | 7 | 14 | 12 | 5 | 10 | 11 | 1 | 2 | 1 | 1 | 6 | 2 | 0 | 0 | 3 | 5 | 3 | 9 |
| Bud Neck | 0 | 0 | 0 | 0 | 0 | 0 | 1 | 0 | 0 | 1 | 0 | 0 | 0 | 3 | 2 | 0 | 2 | 1 | 1 | 2 | 4 | 7 | 8 | 11 |
| Bud Site | 0 | 0 | 0 | 0 | 0 | 0 | 1 | 1 | 1 | 0 | 0 | 1 | 0 | 0 | 0 | 1 | 0 | 0 | – | – | – | – | – | – |
| Cell Periphery | 0 | 1 | 0 | 8 | 8 | 6 | 8 | 17 | 7 | 7 | 4 | 10 | 4 | 10 | 13 | 50 | 44 | 46 | 0 | 0 | 6 | 6 | 2 | 7 |
| Cytoplasm | 14 | 20 | 140 | 118 | 209 | 154 | 294 | 305 | 145 | 219 | 100 | 175 | 212 | 312 | 364 | 68 | 67 | 77 | 25 | 26 | 44 | 61 | 81 | 119 |
| Endoplasmic Reticulum | 3 | 3 | 11 | 8 | 18 | 19 | 18 | 15 | 8 | 11 | 9 | 8 | 15 | 18 | 9 | 2 | 6 | 7 | 7 | 11 | 51 | 27 | 31 | 46 |
| Endosome | 0 | 1 | 2 | 1 | 11 | 1 | 3 | 5 | 3 | 2 | 0 | 1 | 1 | 1 | 1 | 1 | 2 | 1 | 0 | 2 | 3 | 2 | 0 | 8 |
| Golgi | 0 | 0 | 0 | 0 | 0 | 0 | 0 | 0 | 0 | 0 | 0 | 0 | 1 | 0 | 0 | 0 | 2 | 3 | 1 | 2 | 2 | 1 | 1 | 4 |
| Mitochondria | 0 | 0 | 8 | 9 | 27 | 79 | 190 | 210 | 131 | 179 | 143 | 198 | 0 | 0 | 0 | 10 | 13 | 15 | 10 | 7 | 30 | 44 | 31 | 41 |
| Nucleus | 1 | 0 | 1 | 0 | 2 | 1 | 3 | 4 | 0 | 5 | 1 | 1 | 0 | 1 | 1 | 3 | 0 | 1 | 0 | 0 | 0 | 1 | 0 | 1 |
| Nuclear Periphery | 1 | 0 | 0 | 0 | 0 | 0 | 0 | 3 | 0 | 2 | 0 | 2 | 0 | 0 | 0 | 0 | 0 | 0 | 0 | 0 | 0 | 0 | 1 | 2 |
| Nucleolus | 0 | 0 | 0 | 0 | 0 | 0 | 0 | 0 | 0 | 1 | 0 | 1 | 0 | 0 | 0 | 0 | 0 | 0 | 0 | 0 | 0 | 0 | 0 | 0 |
| Peroxisomes | 0 | 0 | 1 | 0 | 5 | 0 | 0 | 1 | 0 | 1 | 2 | 0 | 0 | 0 | 0 | 0 | 0 | 3 | 0 | 0 | 0 | 0 | 0 | 0 |
| SpindlePole | 0 | 0 | 0 | 1 | 1 | 0 | 5 | 8 | 0 | 1 | 0 | 3 | 0 | 0 | 0 | 1 | 3 | 1 | 0 | 2 | 0 | 0 | 0 | 3 |
| Vac/Vac Membrane | 1 | 0 | 1 | 2 | 7 | 4 | 2 | 14 | 7 | 11 | 2 | 5 | 0 | 2 | 3 | 1 | 7 | 14 | 1 | 3 | 4 | 13 | 22 | 33 |
| Unique Cell Count | 20 | 22 | 161 | 135 | 261 | 226 | 441 | 496 | 255 | 368 | 213 | 332 | 231 | 340 | 381 | 147 | 170 | 170 | 52 | 69 | 182 | 182 | 201 | 318 |
| Labelled Cell Count | 21 | 25 | 170 | 151 | 292 | 276 | 532 | 600 | 318 | 447 | 272 | 416 | 236 | 356 | 395 | 169 | 201 | 206 | 52 | 69 | 182 | 182 | 201 | 318 |
Yeast GFP Assignment
Protein Abundance
| Screen | WT1 | WT2 | WT3 | RAP60 | RAP140 | RAP220 | RAP300 | RAP380 | RAP460 | RAP540 | RAP620 | RAP700 | HU80 | HU120 | HU160 | rpd3Δ_1 | rpd3Δ_2 | rpd3Δ_3 | AF100 | AF140 | AF180 |
|---|---|---|---|---|---|---|---|---|---|---|---|---|---|---|---|---|---|---|---|---|---|
| Mean Cell GFP Intensity (1e-4) | 4.2 | 5.9 | 4.8 | 4.9 | 4.8 | 4.3 | 3.8 | 4.0 | 3.6 | 3.6 | 3.6 | 3.5 | 6.2 | 5.8 | 5.9 | 8.4 | 8.2 | 8.3 | 6.5 | 6.6 | 6.6 |
| Std Deviation (1e-4) | 0.4 | 1.6 | 2.1 | 2.3 | 2.1 | 1.7 | 1.9 | 1.5 | 0.9 | 1.3 | 1.3 | 1.4 | 1.3 | 1.2 | 1.2 | 1.6 | 1.6 | 1.5 | 1.7 | 1.9 | 1.9 |
| Intensity Change (Log2) | – | – | – | 0.01 | -0.02 | -0.17 | -0.36 | -0.28 | -0.43 | -0.42 | -0.42 | -0.46 | 0.36 | 0.26 | 0.28 | 0.81 | 0.76 | 0.79 | 0.42 | 0.44 | 0.45 |
Localization Change
| Localization | RAP60 | RAP140 | RAP220 | RAP300 | RAP380 | RAP460 | RAP540 | RAP620 | RAP700 | HU80 | HU120 | HU160 | rpd3Δ_1 | rpd3Δ_2 | rpd3Δ_3 |
|---|---|---|---|---|---|---|---|---|---|---|---|---|---|---|---|
| Cortical Patches | 0 | 0 | 0 | 0 | 0 | 0 | 0 | 0 | 0 | 0 | 0 | 0 | 5.4 | 6.7 | 5.3 |
| Bud | 0 | 0 | 0 | 0 | 0 | 0 | 0 | 0 | 0 | 0 | 0 | 0 | 0 | 0 | 0 |
| Bud Neck | 0 | 0 | 0 | 0 | 0 | 0 | 0 | 0 | 0 | 0 | 0 | 0 | 0 | 0 | 0 |
| Bud Site | 0 | 0 | 0 | 0 | 0 | 0 | 0 | 0 | 0 | 0 | 0 | 0 | 0 | 0 | 0 |
| Cell Periphery | 0 | 0 | 0 | 0 | 0 | 0 | 0 | 0 | 0 | 0 | 0 | 0 | 8.1 | 6.9 | 7.1 |
| Cytoplasm | 0.1 | -1.8 | -4.3 | -4.9 | -6.0 | -6.4 | -6.2 | -8.0 | -7.4 | 1.6 | 1.7 | 3.6 | -7.6 | -8.9 | -8.0 |
| Endoplasmic Reticulum | 0 | 0 | 0 | 0 | 0 | 0 | 0 | 0 | 0 | -0.1 | -0.7 | -2.5 | -2.4 | -1.4 | -1.1 |
| Endosome | 0 | 0 | 0 | 0 | 0 | 0 | 0 | 0 | 0 | 0 | 0 | 0 | 0 | 0 | 0 |
| Golgi | 0 | 0 | 0 | 0 | 0 | 0 | 0 | 0 | 0 | 0 | 0 | 0 | 0 | 0 | 0 |
| Mitochondria | 0 | 0 | 0 | 0 | 0 | 0 | 0 | 0 | 0 | 0 | 0 | 0 | 0.7 | 1.0 | 1.4 |
| Nucleus | 0 | 0 | 0 | 0 | 0 | 0 | 0 | 0 | 0 | 0 | 0 | 0 | 0 | 0 | 0 |
| Nuclear Periphery | 0 | 0 | 0 | 0 | 0 | 0 | 0 | 0 | 0 | 0 | 0 | 0 | 0 | 0 | 0 |
| Nucleolus | 0 | 0 | 0 | 0 | 0 | 0 | 0 | 0 | 0 | 0 | 0 | 0 | 0 | 0 | 0 |
| Peroxisomes | 0 | 0 | 0 | 0 | 0 | 0 | 0 | 0 | 0 | 0 | 0 | 0 | 0 | 0 | 0 |
| SpindlePole | 0 | 0 | 0 | 0 | 0 | 0 | 0 | 0 | 0 | 0 | 0 | 0 | 0 | 0 | 0 |
| Vacuole | 0 | 0 | 0 | 0 | 0 | 0 | 0 | 0 | 0 | 0 | 0 | 0 | 0 | 0 | 3.3 |
External localization resources
Images






























Protein Concentration and Protein Localization Data
| R1 | R2 | R3 | ||||||||||||||||
|---|---|---|---|---|---|---|---|---|---|---|---|---|---|---|---|---|---|---|
| G1 Pre-START | G1 Post-START | S/G2 | Metaphase | Anaphase | Telophase | G1 Pre-START | G1 Post-START | S/G2 | Metaphase | Anaphase | Telophase | G1 Pre-START | G1 Post-START | S/G2 | Metaphase | Anaphase | Telophase | |
| Concentration | – | – | – | – | – | – | – | – | – | – | – | – | – | – | – | – | – | – |
| Actin | 0.059 | 0.0037 | 0.0366 | 0.1334 | 0.0553 | 0.0069 | 0.0485 | 0.0018 | 0.0345 | 0.0698 | 0.0078 | 0.0219 | 0.005 | 0.0019 | 0.0141 | 0 | 0.0002 | 0.0004 |
| Bud | 0.0007 | 0.0008 | 0.0007 | 0.0002 | 0.0016 | 0.0003 | 0.0005 | 0.0002 | 0.0006 | 0.012 | 0.0003 | 0.0009 | 0.0014 | 0.0001 | 0.0005 | 0 | 0 | 0 |
| Bud Neck | 0.0065 | 0.0012 | 0.0068 | 0.0051 | 0.0175 | 0.0098 | 0.0018 | 0.0012 | 0.0027 | 0.0015 | 0.0041 | 0.0072 | 0.0002 | 0.0006 | 0.0472 | 0 | 0.001 | 0.0031 |
| Bud Periphery | 0.0017 | 0.0019 | 0.0025 | 0.0005 | 0.0061 | 0.0011 | 0.0007 | 0.0003 | 0.0016 | 0.0112 | 0.0008 | 0.0027 | 0.0048 | 0.0004 | 0.0024 | 0 | 0 | 0.0001 |
| Bud Site | 0.0055 | 0.0357 | 0.0157 | 0.0017 | 0.0061 | 0.0034 | 0.0026 | 0.0201 | 0.0087 | 0.0638 | 0.0041 | 0.003 | 0.0018 | 0.0044 | 0.0102 | 0 | 0 | 0.0001 |
| Cell Periphery | 0.0185 | 0.0179 | 0.0233 | 0.0052 | 0.0112 | 0.0051 | 0.0042 | 0.0075 | 0.011 | 0.0013 | 0.0057 | 0.0041 | 0.0029 | 0.0059 | 0.0659 | 0 | 0.0011 | 0.0021 |
| Cytoplasm | 0.2345 | 0.3754 | 0.3578 | 0.3215 | 0.3745 | 0.3235 | 0.2085 | 0.3919 | 0.3573 | 0.237 | 0.5266 | 0.43 | 0.2787 | 0.4104 | 0.551 | 0.0016 | 0.4407 | 0.432 |
| Cytoplasmic Foci | 0.0248 | 0.0232 | 0.0568 | 0.0096 | 0.0231 | 0.0241 | 0.0477 | 0.0337 | 0.0305 | 0.0219 | 0.0168 | 0.0354 | 0.0179 | 0.0237 | 0.0139 | 0.0003 | 0.0042 | 0.0081 |
| Eisosomes | 0.0044 | 0.001 | 0.003 | 0.0041 | 0.0024 | 0.0005 | 0.0016 | 0.0005 | 0.001 | 0.0015 | 0.0003 | 0.0004 | 0.0006 | 0.0003 | 0.0031 | 0.0003 | 0.0001 | 0.0001 |
| Endoplasmic Reticulum | 0.1202 | 0.1178 | 0.1196 | 0.3492 | 0.2004 | 0.1525 | 0.0569 | 0.0449 | 0.067 | 0.0123 | 0.1018 | 0.0811 | 0.0203 | 0.0513 | 0.0552 | 0.0001 | 0.0057 | 0.2753 |
| Endosome | 0.0257 | 0.0101 | 0.022 | 0.0036 | 0.0469 | 0.0214 | 0.0235 | 0.0248 | 0.0144 | 0.043 | 0.0276 | 0.0094 | 0.0152 | 0.0094 | 0.0037 | 0 | 0.0004 | 0.0082 |
| Golgi | 0.0108 | 0.0051 | 0.0099 | 0.0053 | 0.0106 | 0.006 | 0.0079 | 0.0093 | 0.0087 | 0.0438 | 0.0163 | 0.0064 | 0.0038 | 0.0015 | 0.0046 | 0 | 0.0001 | 0.0022 |
| Lipid Particles | 0.0273 | 0.008 | 0.0381 | 0.0019 | 0.0106 | 0.0158 | 0.0415 | 0.0281 | 0.0118 | 0.0251 | 0.0103 | 0.0069 | 0.0172 | 0.0301 | 0.0101 | 0.0001 | 0.0005 | 0.0242 |
| Mitochondria | 0.0021 | 0.0034 | 0.0032 | 0.0005 | 0.0076 | 0.0014 | 0.0015 | 0.0018 | 0.0028 | 0.0563 | 0.0013 | 0.0049 | 0.0981 | 0.0001 | 0.0006 | 0 | 0.0001 | 0.0003 |
| None | 0.4239 | 0.38 | 0.2829 | 0.1526 | 0.1709 | 0.4194 | 0.5227 | 0.4254 | 0.4344 | 0.3159 | 0.257 | 0.3767 | 0.5133 | 0.429 | 0.2095 | 0.9973 | 0.5445 | 0.2392 |
| Nuclear Periphery | 0.0148 | 0.0026 | 0.0036 | 0.0013 | 0.0215 | 0.0019 | 0.0062 | 0.0012 | 0.0013 | 0.0029 | 0.0074 | 0.0008 | 0.0009 | 0.0016 | 0.0015 | 0.0001 | 0.0001 | 0.0014 |
| Nucleolus | 0.0007 | 0.001 | 0.0008 | 0.0002 | 0.0021 | 0.0002 | 0.0005 | 0.0003 | 0.0005 | 0.0008 | 0.0005 | 0.0003 | 0.0021 | 0.0003 | 0.0003 | 0 | 0.0001 | 0 |
| Nucleus | 0.0036 | 0.0021 | 0.0022 | 0.0005 | 0.0112 | 0.0012 | 0.0103 | 0.0008 | 0.0008 | 0.0034 | 0.0025 | 0.0007 | 0.0015 | 0.001 | 0.0013 | 0 | 0.0004 | 0.0006 |
| Peroxisomes | 0.0064 | 0.0013 | 0.0049 | 0.0009 | 0.0008 | 0.0005 | 0.0051 | 0.0007 | 0.0048 | 0.0661 | 0.0008 | 0.0026 | 0.004 | 0.0002 | 0.0003 | 0 | 0 | 0.0001 |
| Punctate Nuclear | 0.0035 | 0.0029 | 0.0025 | 0.0004 | 0.0038 | 0.0014 | 0.0036 | 0.0008 | 0.001 | 0.0011 | 0.0038 | 0.0016 | 0.0008 | 0.0008 | 0.0003 | 0.0001 | 0.0001 | 0.0002 |
| Vacuole | 0.0044 | 0.0045 | 0.0067 | 0.0022 | 0.013 | 0.0032 | 0.0039 | 0.0044 | 0.0043 | 0.0073 | 0.0035 | 0.0026 | 0.0084 | 0.0264 | 0.0039 | 0 | 0.0005 | 0.0022 |
| Vacuole Periphery | 0.0011 | 0.0004 | 0.0006 | 0.0001 | 0.0028 | 0.0004 | 0.0004 | 0.0003 | 0.0003 | 0.002 | 0.0008 | 0.0004 | 0.0009 | 0.0005 | 0.0003 | 0 | 0 | 0.0002 |
Sequencing Data
| R1 | R2 | |||||||||
|---|---|---|---|---|---|---|---|---|---|---|
| G1 Post-START | S/G2 | Metaphase | Anaphase | Telophase | G1 Post-START | S/G2 | Metaphase | Anaphase | Telophase | |
| Gene Expression | 65.8076 | 33.8462 | 23.9194 | 39.6039 | 36.2328 | 50.4546 | 40.333 | 36.846 | 42.4855 | 52.9113 |
| Translational Efficiency | 1.2231 | 1.6791 | 1.868 | 1.2611 | 1.78 | 1.4574 | 1.2932 | 1.1219 | 1.1411 | 1.3451 |
Hit Data
| Dataset | Hit |
|---|---|
| Protein Concentration | – |
| Protein Localization | ✘ |
| Gene Expression | ✔ |
| Translational Efficiency | ✘ |
Endocytosis
| Temp | Actin Patch (Sac6-tdTomato) | Cortical Patch (Sla1-GFP) | Late Endosome (Snf7-GFP) | Vacuole (Vph1-GFP) |
|---|---|---|---|---|
| 37℃ | ||||
| RT |
Cell Cycle Omics
CYCLoPs (Ilm1-GFP)
| Gene / Allele | Actin Patch (Sac6-tdTomato) | Cortical Patch (Sla1-GFP) | Late Endosome (Snf7-GFP) | Vacuole (Sac6-tdTomato) |
|---|
| Gene | Images |
|---|
| Gene | Images |
|---|
Images are not yet available
Images are not yet available